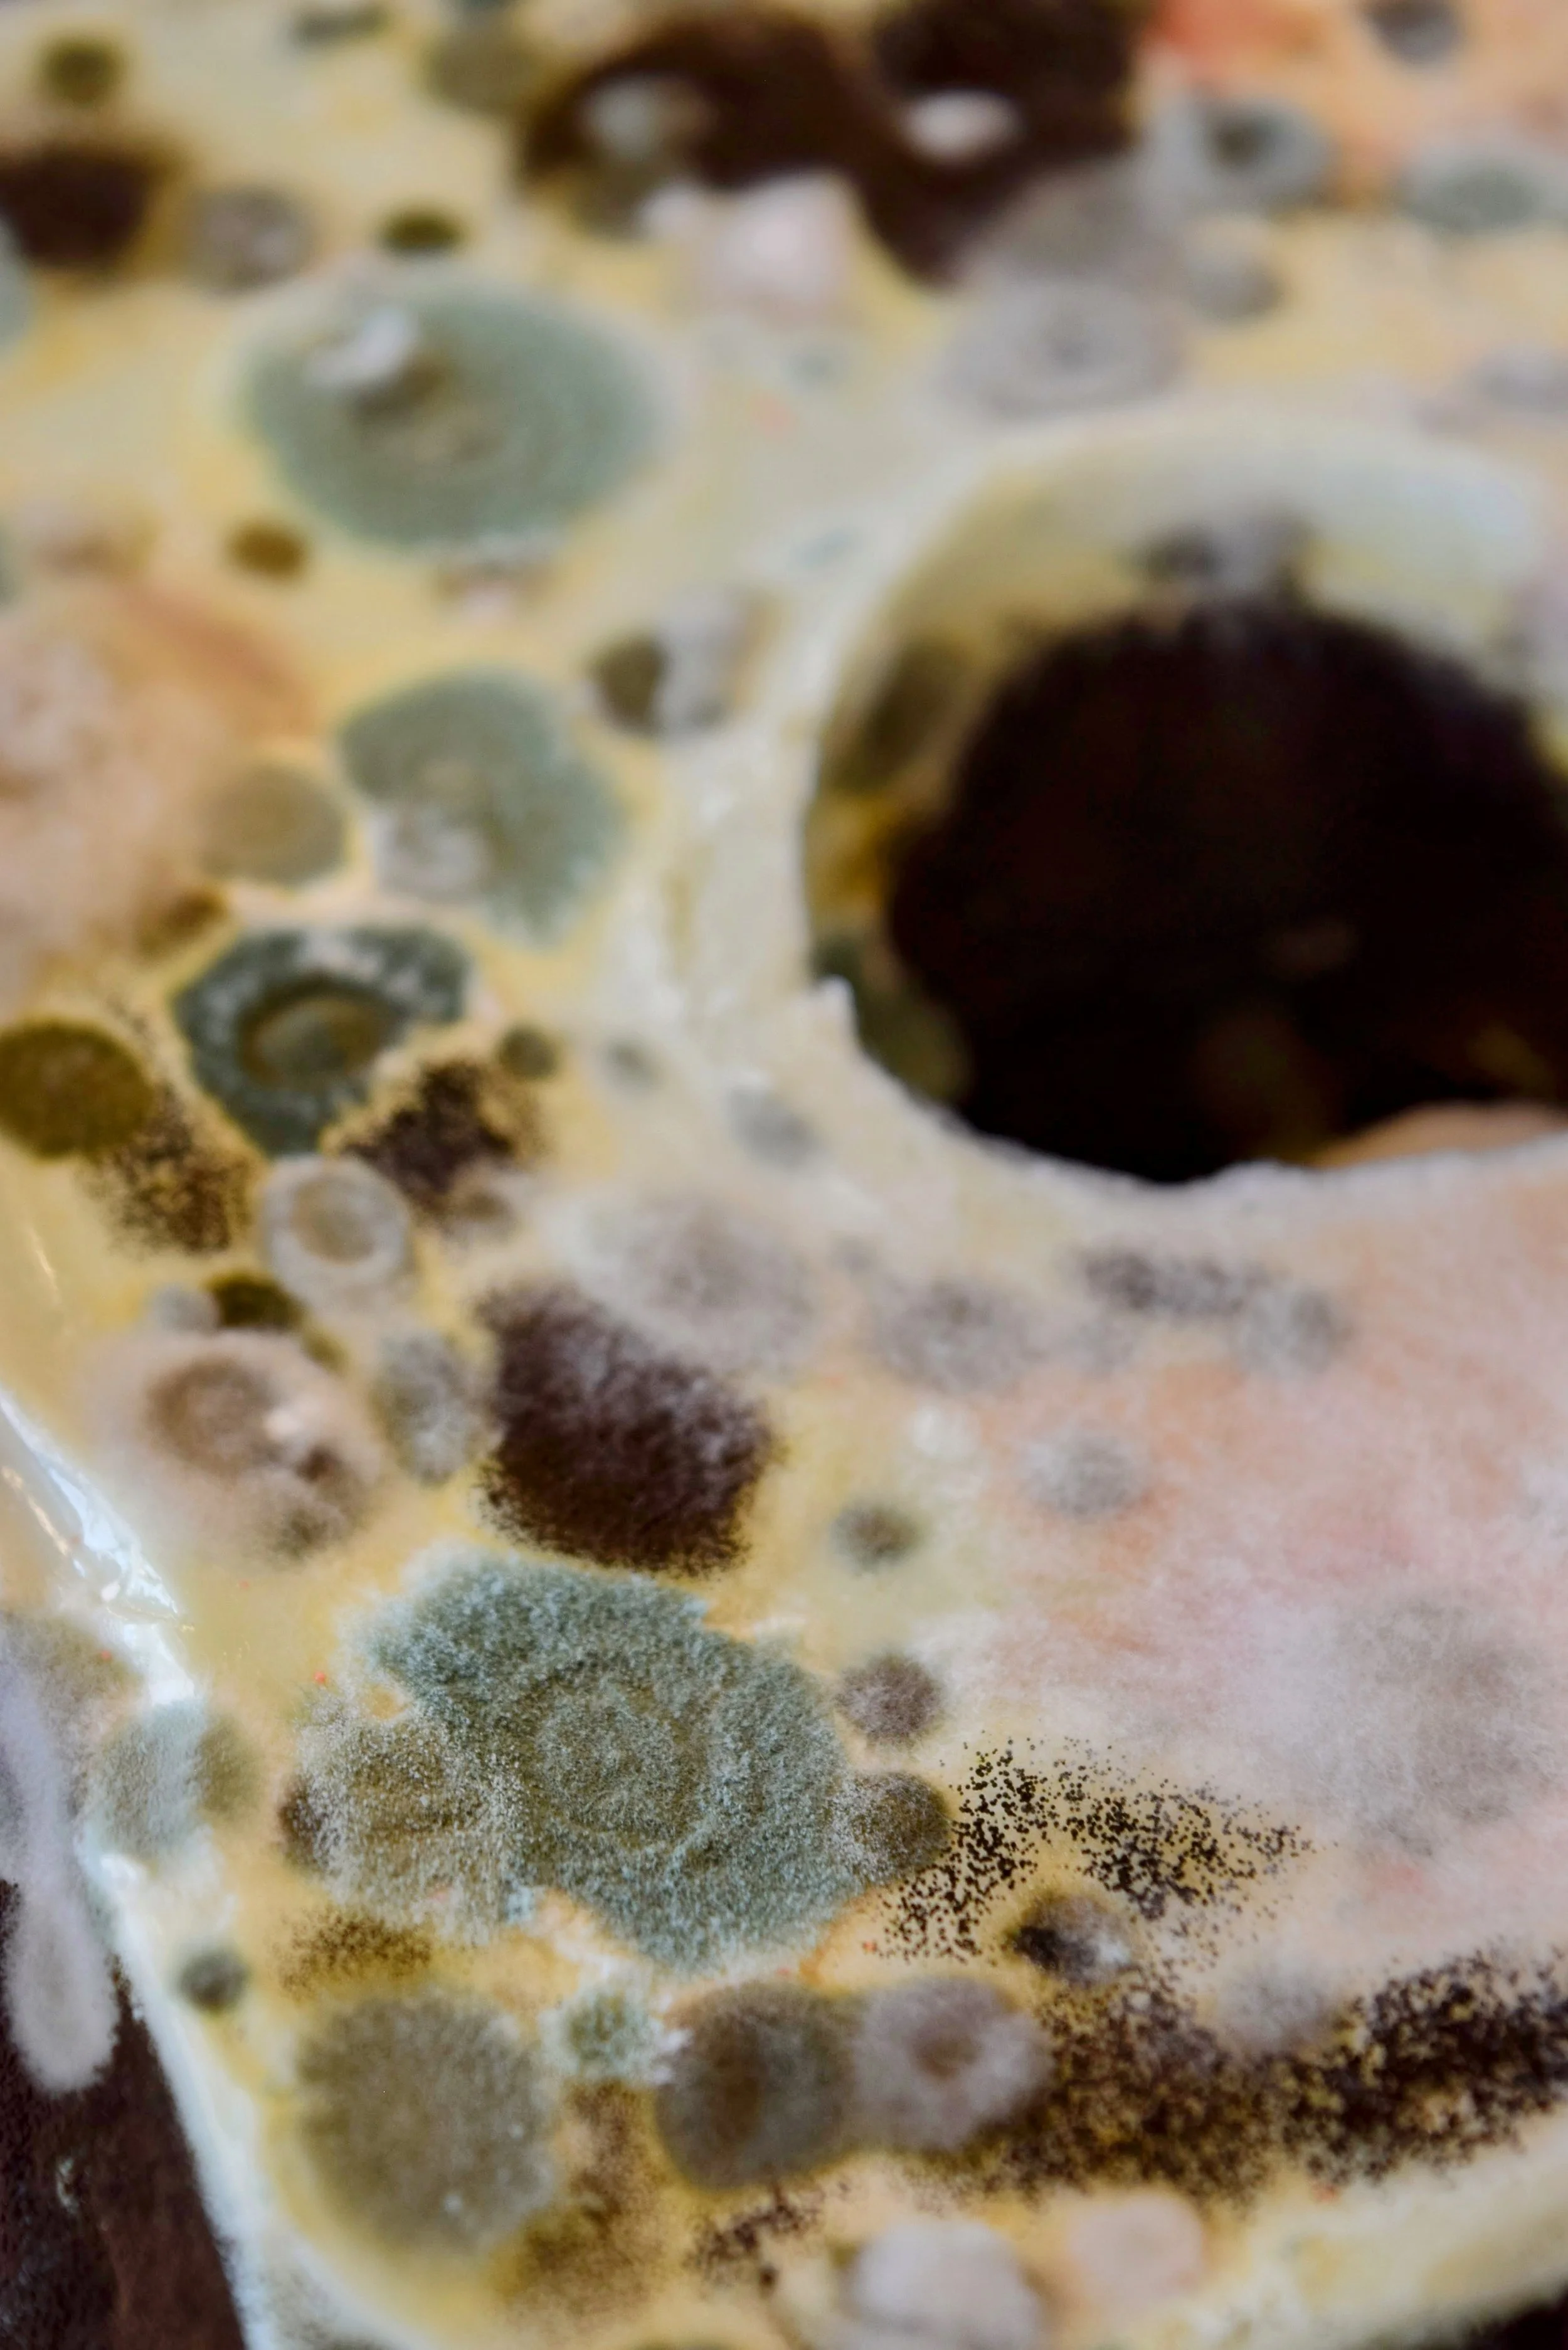

P.I.V ²
[ Penile Inversion Vaginoplasty ]

Animal Gelatine, Glass, Mycofoam
PIV prompts a reevaluation of gender construction and dismantles gendered assumptions about the reproductive body, value, and culture, ultimately inspiring a vision of a more inclusive society.PIV speaks to the gendered misconstructions of the reproductive body through its use of gelatinous biopolymer material. By casting a replica of my own phallus, a hole is left in the center of the cube, drawing attention to the ways in which traditional sex roles have centered around the phallus as a symbol of power and dominance. As the biopolymer material decays, it metaphorically ”digests” society's preconceived notions of sex and culture, encouraging viewers to question and challenge these misconceptions.
PIV's soft architecture of decay serves as a receptacle for society's preconceived notions of sex, gender, value, and time, inviting us to question these misconstructions and work towards a more inclusive and just society. Through PIV, we are called to rethink the ways in which gender is constructed and to challenge the gendered assumptions that underpin our understanding of the reproductive body.